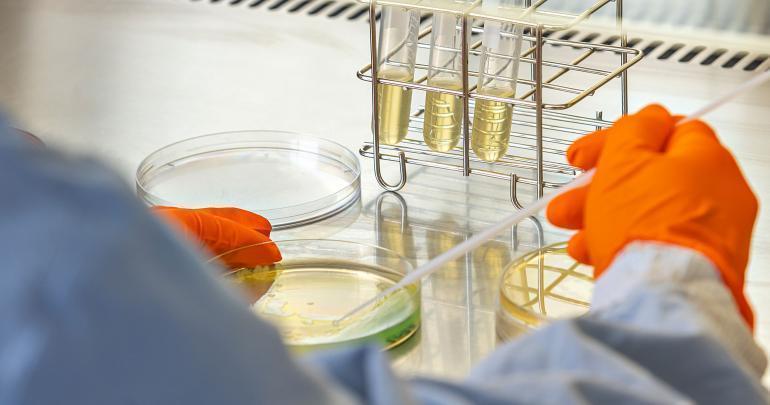

321 M€ levés en Occitanie en 2023
« La transition énergétique est devenue un moteur fort des investissements en Occitanie, avec des levées structurantes opérées par Elements (50 M€) et Ascendance Flight Technologies (21 M€), ainsi que la santé avec Antabio (25 M€), commente Rodolphe Lilamand, en charge des levées au sein d’In Extenso Innovation Croissance, en dévoilant les résultats du baromètre 2023* publié le 22 janvier. Au total, 321 M€ ont été investis en 2023 en Occitanie dans le cadre de 47 tours de table. Comme au national, les levées régionales sont en baisse par rapport à 2022 : - 16 % en nombre d’opérations (56), - 18 % en montants levés (393 M€). Et le ticket moyen (7,7 M€) recule de 5 %. L’Occitanie « démontre sa résilience », selon In Extenso.
Les levées de fonds ont principalement été réalisées dans l’Hérault (123 M€) et en Haute-Garonne (147 M€). « De bonnes nouvelles en perspectives également pour l’amorçage, avec le renforcement des moyens déployés par les Business Angels en région – Capitole Angels se renforce et Aerospace Angels prend son envol –, dans un contexte de loi de finances 2024 favorable au financement des DeepTech » poursuit Rodolphe Lilamand.
*étude menée avec Essec Business School et France Angels